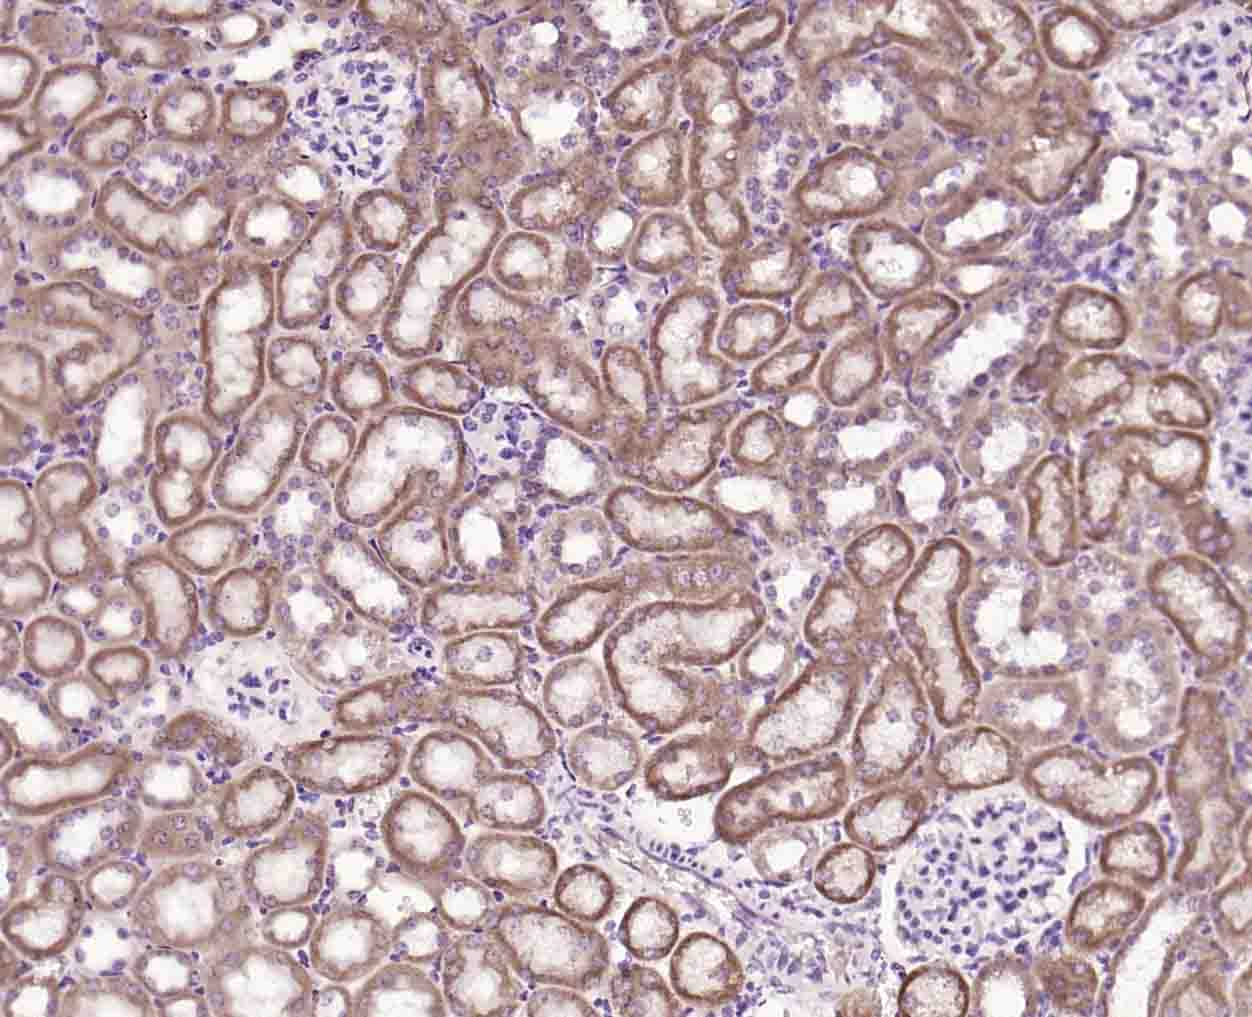
phospho-PLB (Ser16) Rabbit pAb

相关产品推荐更多 >

phospho-FANCD2 (Ser1404) Rabbit pAb, PerCP conjugated(bs-13141R-PerCP)-100ul
¥2980
phospho-c-Jun (Thr93) Rabbit pAb, RBITC conjugated(bs-12913R-RBITC)-100ul
¥2980
CRHBP Rabbit pAb, Biotin conjugated(bs-9906R-Bio)-100ul
¥2980
beta Amyloid 1-42 Rabbit pAb, BF750 conjugated(bs-0107R-BF750)-100ul
¥2980
human CD7 Mouse mAb, APC conjugated(bsm-30009M-APC)-25T/50T/100T
¥1080
万千商家帮你免费找货
0 人在求购买到急需产品
- 详细信息
- 技术资料
- 应用范围:
产品信息以Bioss网站为准
- 规格:
50ul/100ul/200ul
| 规格: | 50ul | 产品价格: | ¥1180.0 |
|---|---|---|---|
| 规格: | 100ul | 产品价格: | ¥1980.0 |
| 规格: | 200ul | 产品价格: | ¥2800.0 |
| 产品编号 | bs-2984R |
| 英文名称 | phospho-PLB (Ser16) Rabbit pAb |
| 中文名称 | 磷酸化心脏磷蛋白抗体 |
| 英文别名 | phospholamban(phospho S16); p-phospholamban(phospho S16); p-PLB(S16); Cardiac phospholamban; CMD1P; PLB; PLN; PPLA_HUMAN. |
| 产品应用 | IHC-P=1:100-500, IHC-F=1:100-500, IF=1:100-500 Not yet tested in other applications. |
| 交叉反应 | Human, Mouse, Rat (Dog, Pig, Cow, Rabbit) |
| 抗体来源 | Rabbit |
| 免疫原 | KLH conjugated synthesised phosphopeptide derived from human Cardiac phospholamban around the phosphorylation site of Ser16 |
| 亚型 | IgG |
| 性状 | Liquid |
| 纯化方法 | affinity purified by Protein A |
| 克隆类型 | Polyclonal |
| 理论分子量 | 5.7 kDa |
| 浓度 | 1mg/ml |
| 储存液 | 0.01M TBS (pH7.4) with 1% BSA, 0.02% Proclin300 and 50% Glycerol. |
| 研究领域 | Cardiovascular > Heart > Contractility > Inotropics Cardiovascular > Vasculature > Vasodilation Signal Transduction > Metabolism > Plasma Membrane > ATPases Signal Transduction > Metabolism > Plasma Membrane > Channels Signal Transduction > Signaling Pathway > Calcium Signaling Signal Transduction > Signaling Pathway > Calcium Signaling > Calcium Channels Tags & Cell Markers > Cell Type Markers > Other Cell Types |
| 亚基 | Homopentamer. Interacts with HAX1. |
| 亚细胞定位 | Mitochondrion membrane; Single-pass membrane protein. Sarcoplasmic reticulum. |
| 组织特异性 | Heart. |
| 翻译后修饰 | Phosphorylated at Thr-17 by CaMK2, and in response to beta-adrenergic stimulation. Phosphorylation by DMPK may stimulate sarcoplasmic reticulum calcium uptake in cardiomyocytes. |
| 相似性 | Belongs to the phospholamban family. |
| 功能 | Phospholamban has been postulated to regulate the activity of the calcium pump of cardiac sarcoplasmic reticulum. |
| 保存条件 | Shipped at 4℃. Store at -20℃ for one year. Avoid repeated freeze/thaw cycles. |
| 注意事项 | This product as supplied is intended for research use only, not for use in human, therapeutic or diagnostic applications. |
| 背景资料 | The Sarco(endo)plasmic-reticulum (SER) regulatory protein, Phospholamban (PLB), is a small, plasma membrane-associated phospho-protein found in the SER of cardiac, smooth and slow-twitch muscle. Believed to assemble into a pentamer, PLB regulates cardiac contractility and Ca2+ affinity for cardiac SER Ca2+ ATPase (SERCA2a). Non-phosphorylated PLB associates with SERCA2a, and inhibits Ca2+ reuptake into the SER. PLB activation occurs when key Serine/Threonine residues in PLB (Ser-10, Ser-16, Thr-17) are phosphorylated by numerous effectors, which include PKC, PKA, PKG, and CaM kinase. Phosphorylation of PLB causes dissociation from SERCA2a and a subsequent increase in the rate of Ca2+ reuptake into the SER, which accelerates ventricular relaxation. |
| 应用 | 推荐稀释比例 |
| {IHC-P} | {1:100-500} |
| {IHC-F} | {1:100-500} |
| {IF} | {1:100-500} |

Paraformaldehyde-fixed, paraffin embedded (rat kidney); Antigen retrieval by boiling in sodium citrate buffer (pH6.0) for 15min; Block endogenous peroxidase by 3% hydrogen peroxide for 20 minutes; Blocking buffer (normal goat serum) at 37°C for 30min; Incubation with (phospho-PLB (Ser16)) Polyclonal Antibody, Unconjugated (bs-2984R) at 1:200 overnight at 4°C, followed by operating according to SP Kit(Rabbit) (sp-0023) instructionsand DAB staining.
Paraformaldehyde-fixed, paraffin embedded (mouse kidney); Antigen retrieval by boiling in sodium citrate buffer (pH6.0) for 15min; Block endogenous peroxidase by 3% hydrogen peroxide for 20 minutes; Blocking buffer (normal goat serum) at 37°C for 30min; Incubation with (phospho-PLB (Ser16)) Polyclonal Antibody, Unconjugated (bs-2984R) at 1:200 overnight at 4°C, followed by operating according to SP Kit(Rabbit) (sp-0023) instructionsand DAB staining.

Paraformaldehyde-fixed, paraffin embedded (human heart); Antigen retrieval by boiling in sodium citrate buffer (pH6.0) for 15min; Block endogenous peroxidase by 3% hydrogen peroxide for 20 minutes; Blocking buffer (normal goat serum) at 37°C for 30min; Incubation with (phospho-PLB (Ser16)) Polyclonal Antibody, Unconjugated (bs-2984R) at 1:200 overnight at 4°C, followed by operating according to SP Kit(Rabbit) (sp-0023) instructionsand DAB staining.
风险提示:丁香通仅作为第三方平台,为商家信息发布提供平台空间。用户咨询产品时请注意保护个人信息及财产安全,合理判断,谨慎选购商品,商家和用户对交易行为负责。对于医疗器械类产品,请先查证核实企业经营资质和医疗器械产品注册证情况。
技术资料暂无技术资料 索取技术资料
phospho-PLB (Ser16) Rabbit pAb(bs-2984R)-50ul/100ul/200ul
¥1180 - 2800





